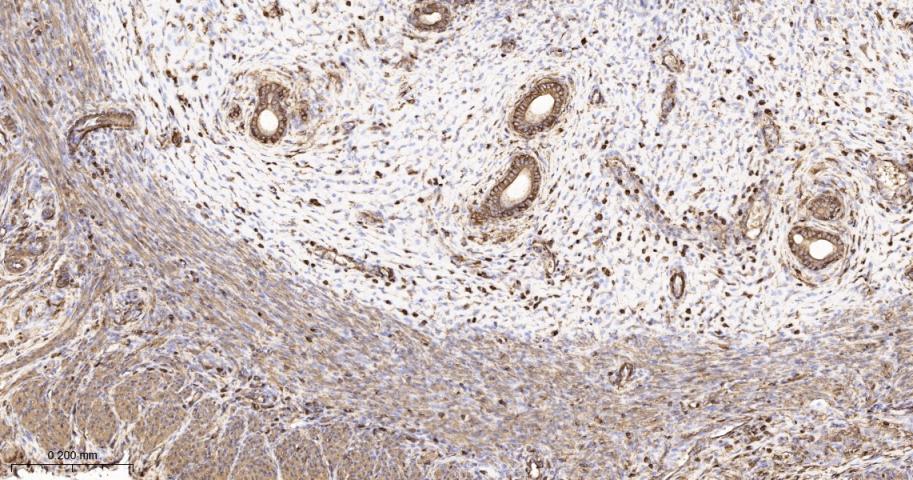
beta Actin Recombinant Rabbit
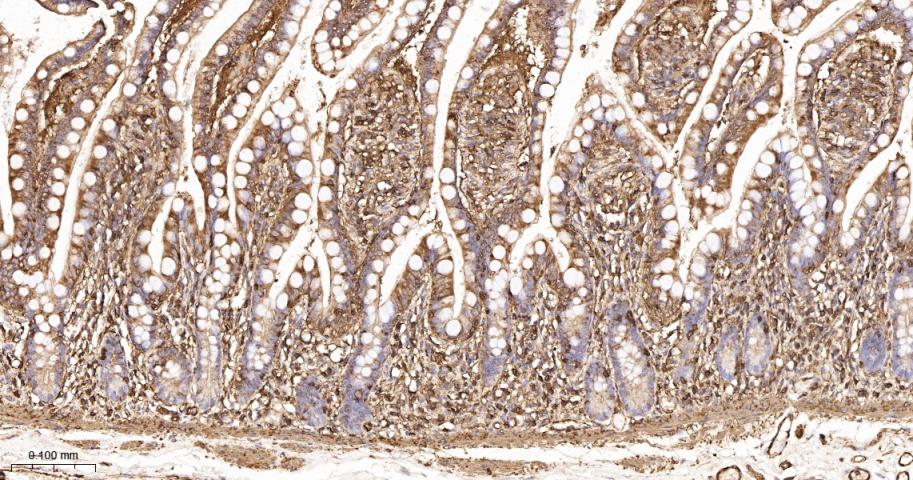
beta Actin Recombinant Rabbit

相关产品推荐更多 >

Symmetric DiMethyl-Histone H3(R17) Recombinant Rabbit mAb(bsm-63233R)-25ul/50ul/100ul
¥800
PTHLH Rabbit pAb, BF647 conjugated(bs-1107R-BF647)-100ul
¥2980
SOCS5 Rabbit pAb, RBITC conjugated(bs-13664R-RBITC)-100ul
¥2980
phospho-IRS1 (Ser616) Rabbit pAb, Biotin conjugated(bs-12710R-Bio)-100ul
¥2980
OTUB2 Rabbit pAb, Biotin conjugated(bs-6236R-Bio)-100ul
¥2980
万千商家帮你免费找货
0 人在求购买到急需产品
- 详细信息
- 文献和实验
- 技术资料
- 应用范围:
产品信息以Bioss网站为准
- 规格:
100ul/200ul/500ul/1000ul
| 规格: | 100ul | 产品价格: | ¥580.0 |
|---|---|---|---|
| 规格: | 200ul | 产品价格: | ¥980.0 |
| 规格: | 500ul | 产品价格: | ¥2280.0 |
| 规格: | 1000ul | 产品价格: | ¥4680.0 |
| 产品编号 | bsm-63325R |
| 英文名称 | beta Actin Recombinant Rabbit mAb |
| 中文名称 | β-肌动蛋白/β-Actin(内参)重组兔单抗 |
| 英文别名 | ACTB_HUMAN; Actin, cytoplasmic 1; ACTB; EC:3.6.4.- ; Beta actin; Actin, cytoplasmic 1, N-terminally processed; actin beta; BNS; CSMH; DDS1; THC8; BKRNS; BRWS1; PS1TP5BP1; Actin cytoplasmic 1; β actin; β-actin; βactin; |
| 中文别名 | β actin; βactin; |
| 产品应用 | WB=1:50000-100000, IHC-P=1:200-1000, IHC-F=1:200-1000, IF=1:200-1000, Flow-Cyt=1ug/Test, ICC/IF=1:100-500 Not yet tested in other applications. |
| 交叉反应 | Human, Mouse, Rat |
| 抗体来源 | Rabbit |
| 免疫原 | A synthesized peptide derived from human beta Actin |
| 亚型 | IgG |
| 性状 | Liquid |
| 纯化方法 | affinity purified by Protein A |
| 克隆类型 | Recombinant |
| 理论分子量 | 42 kDa |
| 浓度 | 1mg/ml |
| 储存液 | 0.01M TBS (pH7.4) with 1% BSA, 0.02% Proclin300 and 50% Glycerol. |
| 研究领域 | Isotype/Loading Controls > Loading Controls > Beta Actin Signal Transduction > Cytoskeleton / ECM > Cytoskeleton > Microfilaments > Actin etc > Actin Tags & Cell Markers > Subcellular Markers > Cytoskeleton > Actin |
| 亚基 | Polymerization of globular actin (G-actin) leads to a structural filament (F-actin) in the form of a two-stranded helix. Each actin can bind to 4 others. Identified in a mRNP granule complex, at least composed of ACTB, ACTN4, DHX9, ERG, HNRNPA1, HNRNPA2B1, HNRNPAB, HNRNPD, HNRNPL, HNRNPR, HNRNPU, HSPA1, HSPA8, IGF2BP1, ILF2, ILF3, NCBP1, NCL, PABPC1, PABPC4, PABPN1, RPLP0, RPS3, RPS3A, RPS4X, RPS8, RPS9, SYNCRIP, TROVE2, YBX1 and untranslated mRNAs. Component of the BAF complex, which includes at least actin (ACTB), ARID1A, ARID1B/BAF250, SMARCA2, SMARCA4/BRG1, ACTL6A/BAF53, ACTL6B/BAF53B, SMARCE1/BAF57 SMARCC1/BAF155, SMARCC2/BAF170, SMARCB1/SNF5/INI1, and one or more of SMARCD1/BAF60A, SMARCD2/BAF60B, or SMARCD3/BAF60C. In muscle cells, the BAF complex also contains DPF3. Found in a complex with XPO6, Ran, ACTB and PFN1. Component of the MLL5-L complex, at least composed of MLL5, STK38, PPP1CA, PPP1CB, PPP1CC, HCFC1, ACTB and OGT. Interacts with XPO6 and EMD. Interacts with ERBB2. |
| 亚细胞定位 | Cytoplasm, cytoskeleton. |
| 组织特异性 | Ubiquitously expressed in all eukaryotic cells. |
| 翻译后修饰 | ISGylated. Oxidation of Met-44 by MICALs (MICAL1, MICAL2 or MICAL3) to form methionine sulfoxide promotes actin filament depolymerization. Methionine sulfoxide is produced stereospecifically, but it is not known whether the (S)-S-oxide or the (R)-S-oxide is produced. |
| 相似性 | Belongs to the actin family. |
| 功能 | Actins are highly conserved proteins that are involved in various types of cell motility and are ubiquitously expressed in all eukaryotic cells. |
| 保存条件 | Shipped at 4℃. Store at -20℃ for one year. Avoid repeated freeze/thaw cycles. |
| 注意事项 | This product as supplied is intended for research use only, not for use in human, therapeutic or diagnostic applications. |
| 背景资料 | Actin is a highly conserved protein and an essential component of cell cytoskeleton and plays an important role in cytoplasmic streaming, cell shape determination, cell division, organelle movement and extension growth. Preferentially expressed in young and expanding tissues, floral organ primordia, developing seeds and emerging inflorescence. Antibodies against plant Actin are useful as loading controls for Western Blotting. |
| 应用 | 推荐稀释比例 |
| {WB} | {1:50000-100000} |
| {IHC-P} | {1:200-1000} |
| {IHC-F} | {1:200-1000} |
| {IF} | {1:200-1000} |
| {Flow-Cyt} | {1ug/Test} |
| {ICC/IF} | {1:100-500} |

Paraformaldehyde-fixed, paraffin embedded Mouse Lung; Antigen retrieval by boiling in sodium citrate buffer (pH6.0) for 15 min; The section was incubated with beta Actin Monoclonal Antibody, Unconjugated (bsm-63325R) at 1:200 overnight at 4°C, followed by conjugation to the bs-0295G-HRP and DAB (C-0010) staining.

Paraformaldehyde-fixed, paraffin embedded Rat Lung; Antigen retrieval by boiling in sodium citrate buffer (pH6.0) for 15 min; The section was incubated with beta Actin Monoclonal Antibody, Unconjugated (bsm-63325R) at 1:200 overnight at 4°C, followed by conjugation to the bs-0295G-HRP and DAB (C-0010) staining.

Paraformaldehyde-fixed, paraffin embedded Mouse Colon; Antigen retrieval by boiling in sodium citrate buffer (pH6.0) for 15 min; The section was incubated with beta Actin Monoclonal Antibody, Unconjugated (bsm-63325R) at 1:200 overnight at 4°C, followed by conjugation to the bs-0295G-HRP and DAB (C-0010) staining.

Paraformaldehyde-fixed, paraffin embedded Rat Colon; Antigen retrieval by boiling in sodium citrate buffer (pH6.0) for 15 min; The section was incubated with beta Actin Monoclonal Antibody, Unconjugated (bsm-63325R) at 1:200 overnight at 4°C, followed by conjugation to the bs-0295G-HRP and DAB (C-0010) staining.

Paraformaldehyde-fixed, paraffin embedded Human Colon; Antigen retrieval by boiling in sodium citrate buffer (pH6.0) for 15 min; The section was incubated with beta Actin Monoclonal Antibody, Unconjugated (bsm-63325R) at 1:200 overnight at 4°C, followed by conjugation to the bs-0295G-HRP and DAB (C-0010) staining.

Paraformaldehyde-fixed, paraffin embedded Mouse Placenta; Antigen retrieval by boiling in sodium citrate buffer (pH6.0) for 15 min; The section was incubated with beta Actin Monoclonal Antibody, Unconjugated (bsm-63325R) at 1:200 overnight at 4°C, followed by conjugation to the bs-0295G-HRP and DAB (C-0010) staining.

Paraformaldehyde-fixed, paraffin embedded Mouse Uterus; Antigen retrieval by boiling in sodium citrate buffer (pH6.0) for 15 min; The section was incubated with beta Actin Monoclonal Antibody, Unconjugated (bsm-63325R) at 1:200 overnight at 4°C, followed by conjugation to the bs-0295G-HRP and DAB (C-0010) staining.
Paraformaldehyde-fixed, paraffin embedded Rat Uterus; Antigen retrieval by boiling in sodium citrate buffer (pH6.0) for 15 min; The section was incubated with beta Actin Monoclonal Antibody, Unconjugated (bsm-63325R) at 1:200 overnight at 4°C, followed by conjugation to the bs-0295G-HRP and DAB (C-0010) staining.

Paraformaldehyde-fixed, paraffin embedded Human Uterus; Antigen retrieval by boiling in sodium citrate buffer (pH6.0) for 15 min; The section was incubated with beta Actin Monoclonal Antibody, Unconjugated (bsm-63325R) at 1:200 overnight at 4°C, followed by conjugation to the bs-0295G-HRP and DAB (C-0010) staining.

Paraformaldehyde-fixed, paraffin embedded Human Lung Cancer; Antigen retrieval by boiling in sodium citrate buffer (pH6.0) for 15 min; The section was incubated with beta Actin Monoclonal Antibody, Unconjugated (bsm-63325R) at 1:200 overnight at 4°C, followed by conjugation to the bs-0295G-HRP and DAB (C-0010) staining.

Paraformaldehyde-fixed, paraffin embedded Human Colon Cancer; Antigen retrieval by boiling in sodium citrate buffer (pH6.0) for 15 min; The section was incubated with beta Actin Monoclonal Antibody, Unconjugated (bsm-63325R) at 1:200 overnight at 4°C, followed by conjugation to the bs-0295G-HRP and DAB (C-0010) staining.

Paraformaldehyde-fixed, paraffin embedded Human Breast Cancer; Antigen retrieval by boiling in sodium citrate buffer (pH6.0) for 15 min; The section was incubated with beta Actin Monoclonal Antibody, Unconjugated (bsm-63325R) at 1:200 overnight at 4°C, followed by conjugation to the bs-0295G-HRP and DAB (C-0010) staining.
Paraformaldehyde-fixed, paraffin embedded Human Small Intestine; Antigen retrieval by boiling in sodium citrate buffer (pH6.0) for 15 min; The section was incubated with beta Actin Monoclonal Antibody, Unconjugated (bsm-63325R) at 1:200 overnight at 4°C, followed by conjugation to the bs-0295G-HRP and DAB (C-0010) staining.

25 ug total protein per lane of various lysates (see on figure) probed with beta Actin monoclonal antibody, unconjugated (bsm-63325R) at 1:50000 dilution and 4°C overnight incubation. Followed by conjugated secondary antibody incubation at r.t. for 60 min.
风险提示:丁香通仅作为第三方平台,为商家信息发布提供平台空间。用户咨询产品时请注意保护个人信息及财产安全,合理判断,谨慎选购商品,商家和用户对交易行为负责。对于医疗器械类产品,请先查证核实企业经营资质和医疗器械产品注册证情况。
 文献和实验
文献和实验该产品被引用文献
[IF={{ 5 }}] {Ganen Wang. et al. Bifidobacterium animalis Subsp. lactis PB200 Improves Intestinal Barrier Function and Flora Disturbance in Mice with Antibiotic-Induced Intestinal Injury. NUTRIENTS. 2025 Jan;17(10):1610} {WB} {Mouse}
 技术资料
技术资料暂无技术资料 索取技术资料
文献支持
beta Actin Recombinant Rabbit mAb(bsm-63325R)-100ul/200ul/500ul/1000ul
¥580 - 4680





